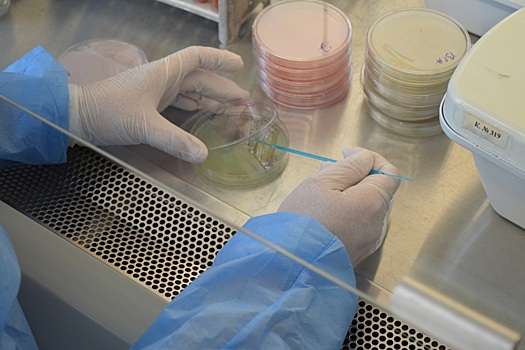
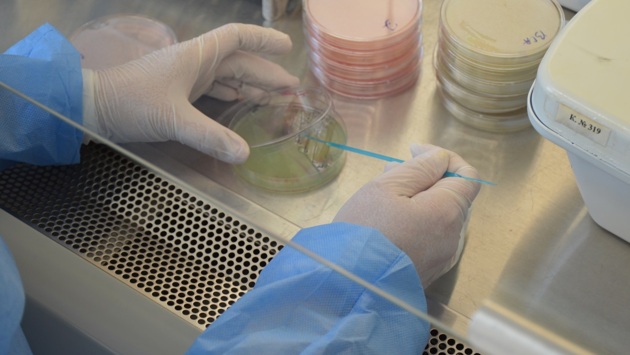

Более десятка редких и экзотических инфекции изучают в лабораторно-диагностическом центре ВНИИЗЖ
Во Всероссийском научно-исследовательском институте здоровья животных (ФГБУ «ВНИИЗЖ»), подведомственном Россельхознадзору, расширили спектр исследований, включив в него не только особо опасные, но и редкие, экзотические инфекции.
Речь идёт о более чем десятке болезней и их разновидностей. Основная часть из них поражает сельскохозяйственных животных, в частности, африканская чума свиней, венесуэльский и японский энцефалиты лошадей, чума крупного рогатого скота, аденоматоз овец, болезнь Акабане, лихорадка Западного Нила и лихорадка долины Рифт.
Кроме того, в перечень вошли болезни птиц (грипп птиц подтипов Н5 и Н7) и заболевания, общие для различных видов животных (бруцеллёз КРС, свиней и собак, чума плотоядных).
Лабораторно-диагностический центр получил аккредитацию на исследования ещё по 29 показателям. Во ВНИИЗЖ подчеркнули, что данная процедура позволила значительно расширить возможности ученых в области диагностики особо опасных, экономически значимых и экзотических инфекционных заболеваний.
На сегодняшний день учреждение располагает аккредитацией на 182 метода исследований, необходимых для выявления болезней, оперативного реагирования на возникающие угрозы, поддержания благополучной эпизоотической обстановки в стране, а также для проведения научных исследований в области диагностики и профилактики инфекционных заболеваний, проинформировала пресс-служба ВНИИЗЖ.
Главврач Осипов не исключил занос желтой лихорадки из Колумбии в Россию.
Минздрав внедрит систему дистанционного мониторинга здоровья пациентов.